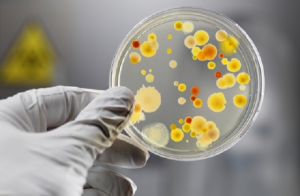

Роспотребнадзор: Об официальном ответе Министерства здравоохранения Турции по ситуации с вирусом Коксаки
Федеральная служба по надзору в сфере защиты прав потребителей и благополучия человека сообщает, что получен ответ на запрос службы от Ведомства народного здравоохранения Министерства здравоохранения Турции по эпидемиологической ситуации в провинции Анталья. Всего за период с июля т.г. в клиники и больницы провинции Анталья по информации органов здравоохранения Турции с различными симптомами обратились 348 человек. С представителями клиник и больниц, администрациями отелей Антальи проведены оперативные переговоры.
Минздравом Турции даны указания на предмет принятия мер по улучшению санитарно-эпидемиологических условий, ведения мониторинга обращений туристов. Будет продолжена тщательная дезинфекция мест общего пользования, в первую очередь бассейнов.
Министерством иностранных дел России, Посольством Российской Федерации в Турецкой Республике и Роспотребнадзором ведутся переговоры с турецкой стороной по координации действий, направленных на стабилизацию ситуации.
Фото Ato-news.info
Другие новости по теме «События»